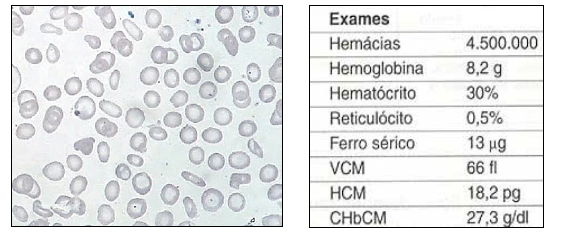
Imagem associada para resolu&ccedil;&atilde;o da quest&atilde;o

Questões do concurso:
Prefeitura de Apiacá - ES - 2016 - IDECAN - 2016 - Prefeitura de Apiacá - ES - Bioquímico
limpar filtros
40 Questões de concurso encontradas
Página 5 de 8
Questões por página:
Questões por página:
Concurso:
Prefeitura de Apiacá - ES
Disciplina:
Biomedicina - Análises Clínicas
Ao analisar o esfregaço de sangue de uma paciente de 13 anos, notou-se anemia microcítica hipocrômica, hemácias em forma de lápis ou cigarro e anisositose.” Os resultados dos exames complementares dessa paciente e o esfregaço sanguíneo apresentam-se a seguir.

De acordo com os dados e as imagens anteriores, é correto afirmar que a paciente apresenta:
De acordo com os dados e as imagens anteriores, é correto afirmar que a paciente apresenta:
Concurso:
Prefeitura de Apiacá - ES
Disciplina:
Biomedicina - Análises Clínicas
Relacione adequadamente as colunas a seguir.
1. Meio de Lowenstein-Jensen.
2. Ágar manitol.
3. Caldo Lim.
4. Ágar cistina-telurito
( ) Seletivo para estafilococos.
( ) Recuperação de Corynebacterium diphtheriae.
( ) Seletivo para micobactérias.
( ) Recuperação de Streptococcus agalactiae
A sequência está correta em
Concurso:
Prefeitura de Apiacá - ES
Disciplina:
Biomedicina - Análises Clínicas
Sobre a presença de cilindros na urina, é INCORRETO afirmar que cilindros
Concurso:
Prefeitura de Apiacá - ES
Disciplina:
Biomedicina - Análises Clínicas
Analise as afirmativas a seguir, marque V para as verdadeiras e F para as falsas. ( ) A bactéria Legionella é um importante patógeno respiratório. Para o isolamente desse organismo, é necessário o uso de um meio suplementado com ferro e L-cisteína. ( ) Chlamydia, uma importante bactéria responsável por doenças sexualmente transmissíveis, é um patógeno intracelular obrigatório que só pode ser cultivado em células vivas (cultura de células). ( ) O meio de cultura Ágar Mueller-Hinton é um meio seletivo do tipo especializado, diferencial para Salmonella. ( ) O Ágar manitol é seletivo para estafilococos, diferencial para Staphylococcus aureus. A sequência está correta em
Concurso:
Prefeitura de Apiacá - ES
Disciplina:
Biomedicina - Análises Clínicas
A macrocitose é uma alteração no tamanho das hemácias, em que a medula óssea produz glóbulos vermelhos gigantes e imaturos. Essa alteração pode ser chamada de anemia megaloblástica ou anemia macrocítica. “Um paciente está com um quadro clínico de glossite, faz ingestão excessiva de álcool e está desnutrido (carência alimentar). Ao analisar uma lâmina de sangue no microscópio deste um paciente, é observado: anemia macrocítica normocrômica, presença de glóbulos vermelhos nucleados, presença de macro-ovalócitos e aumento do espectro de distribuição das hemácias.” Estas características se referem à: